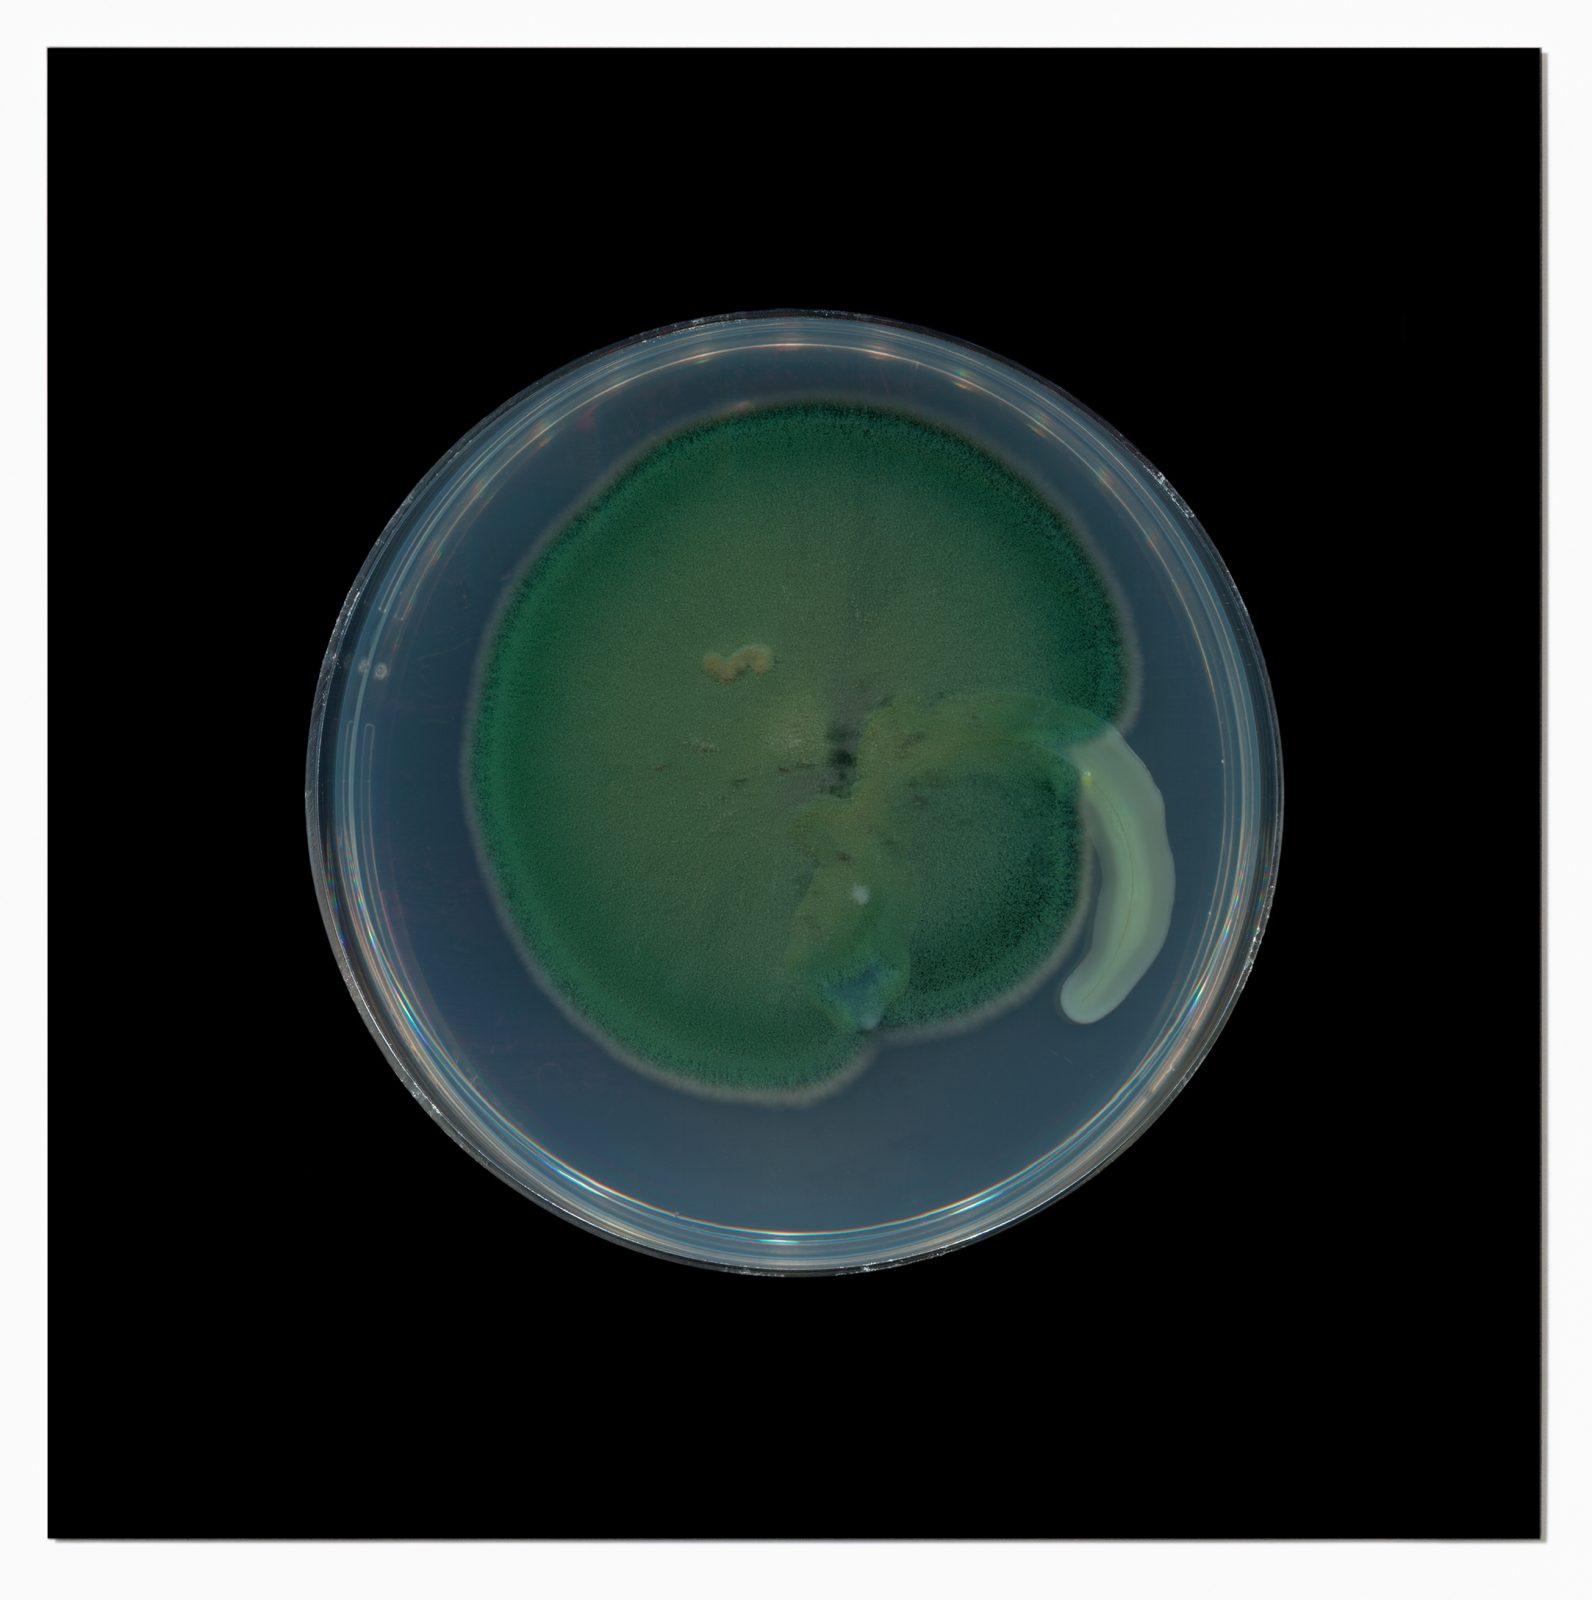
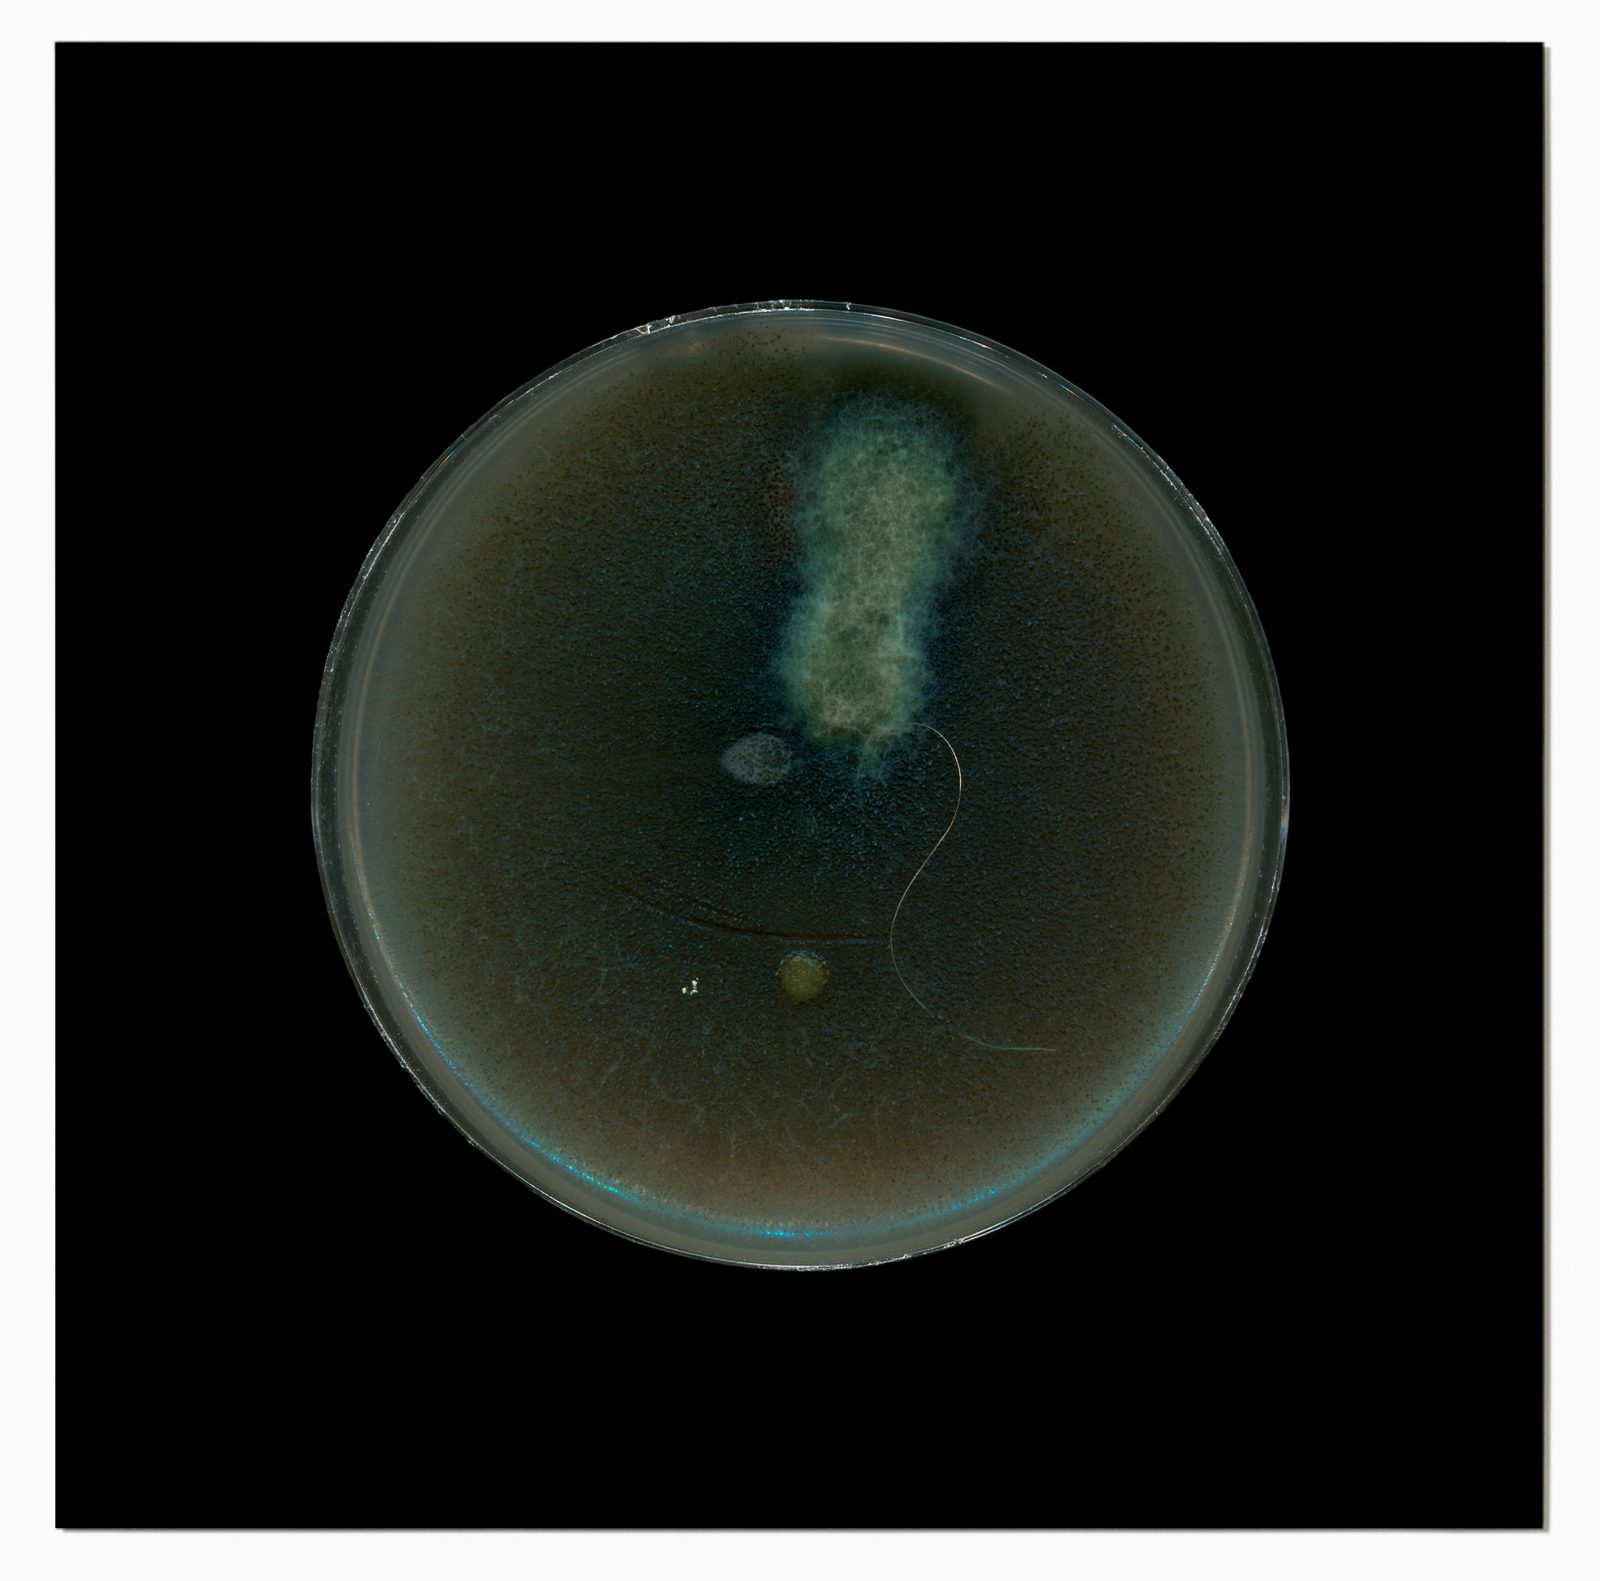
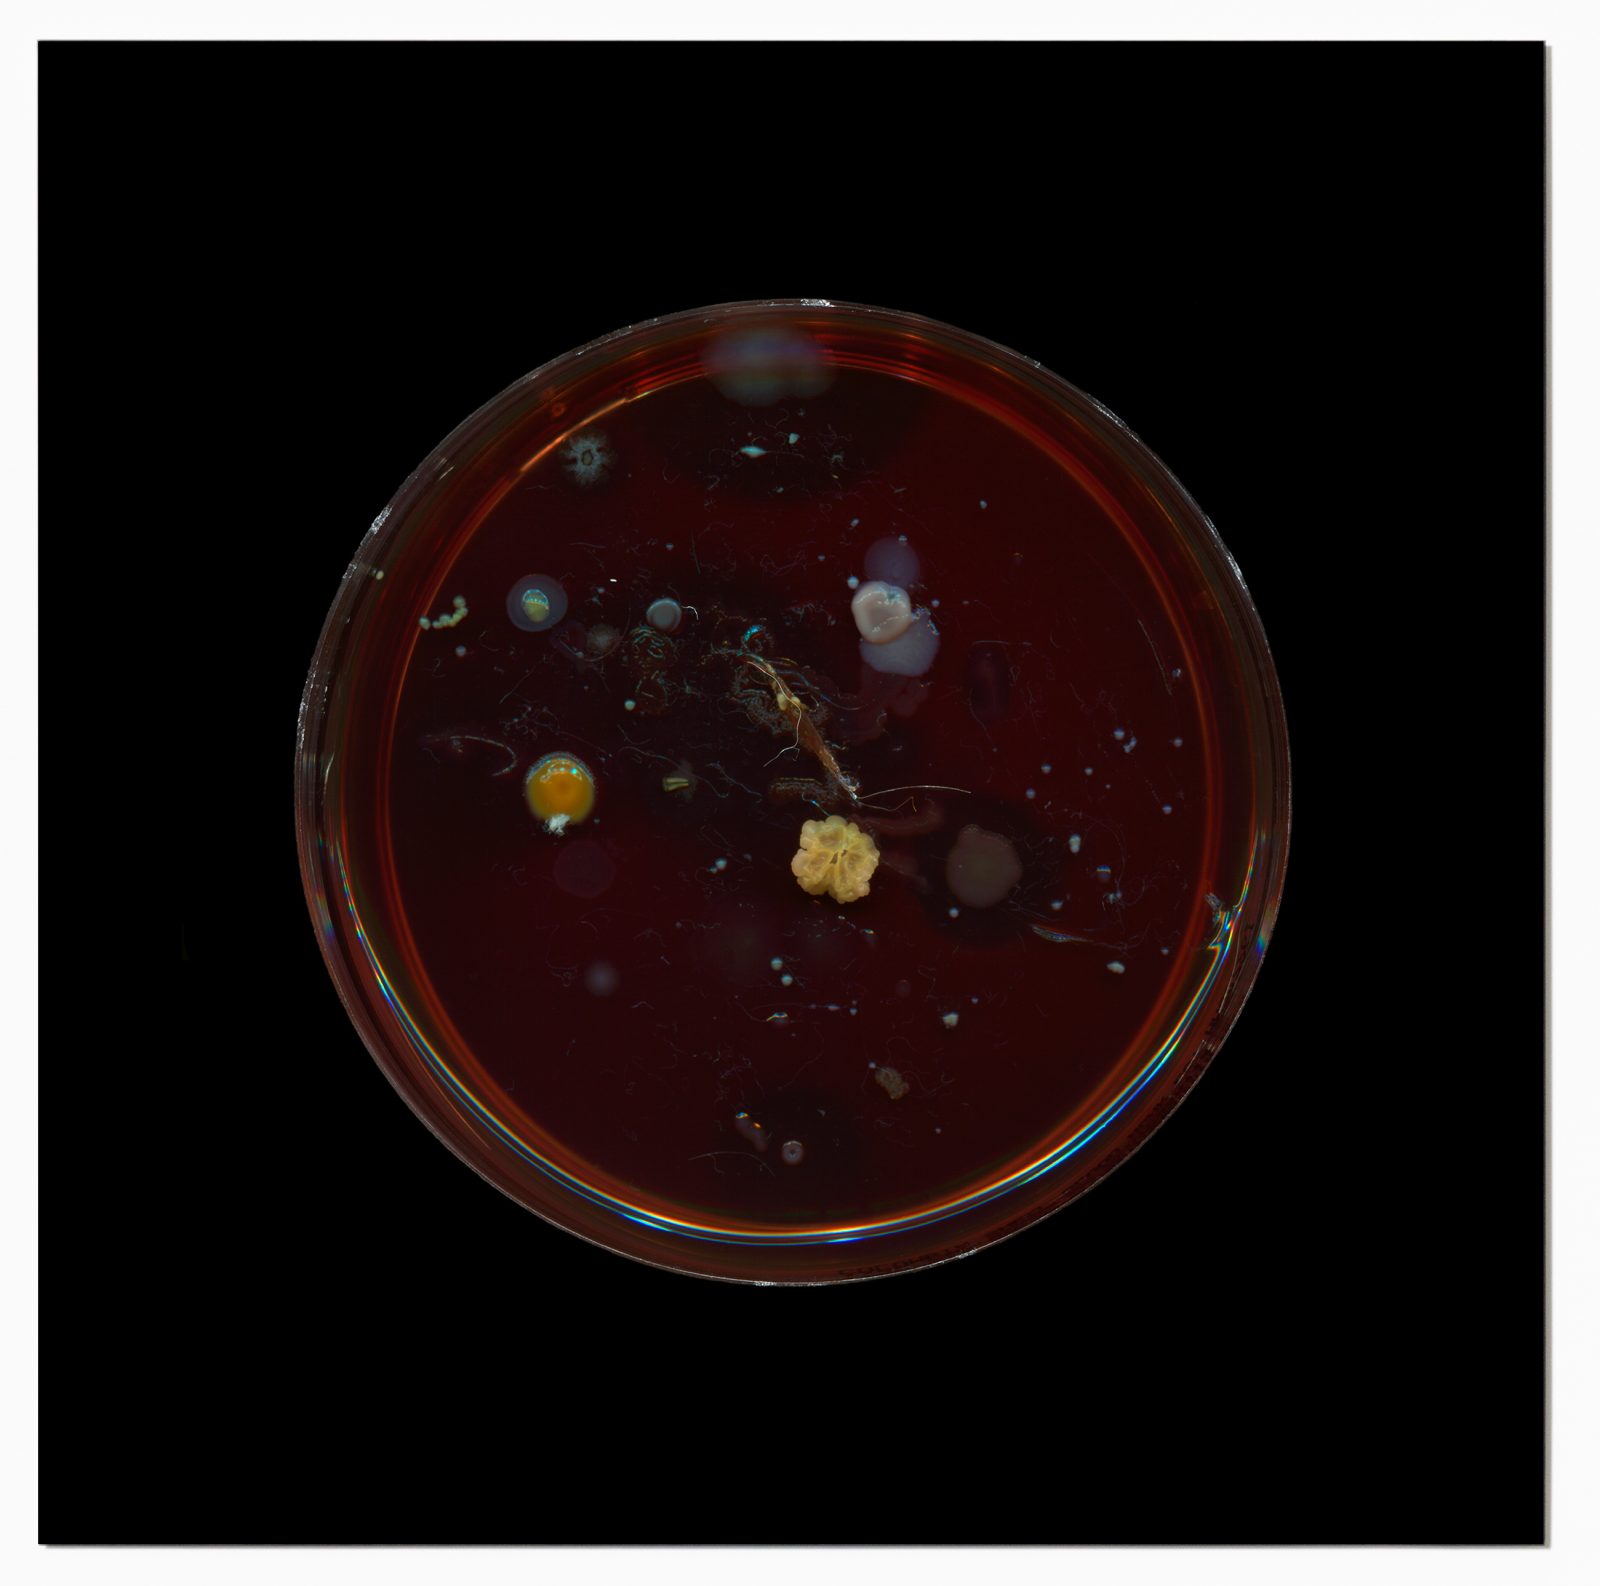
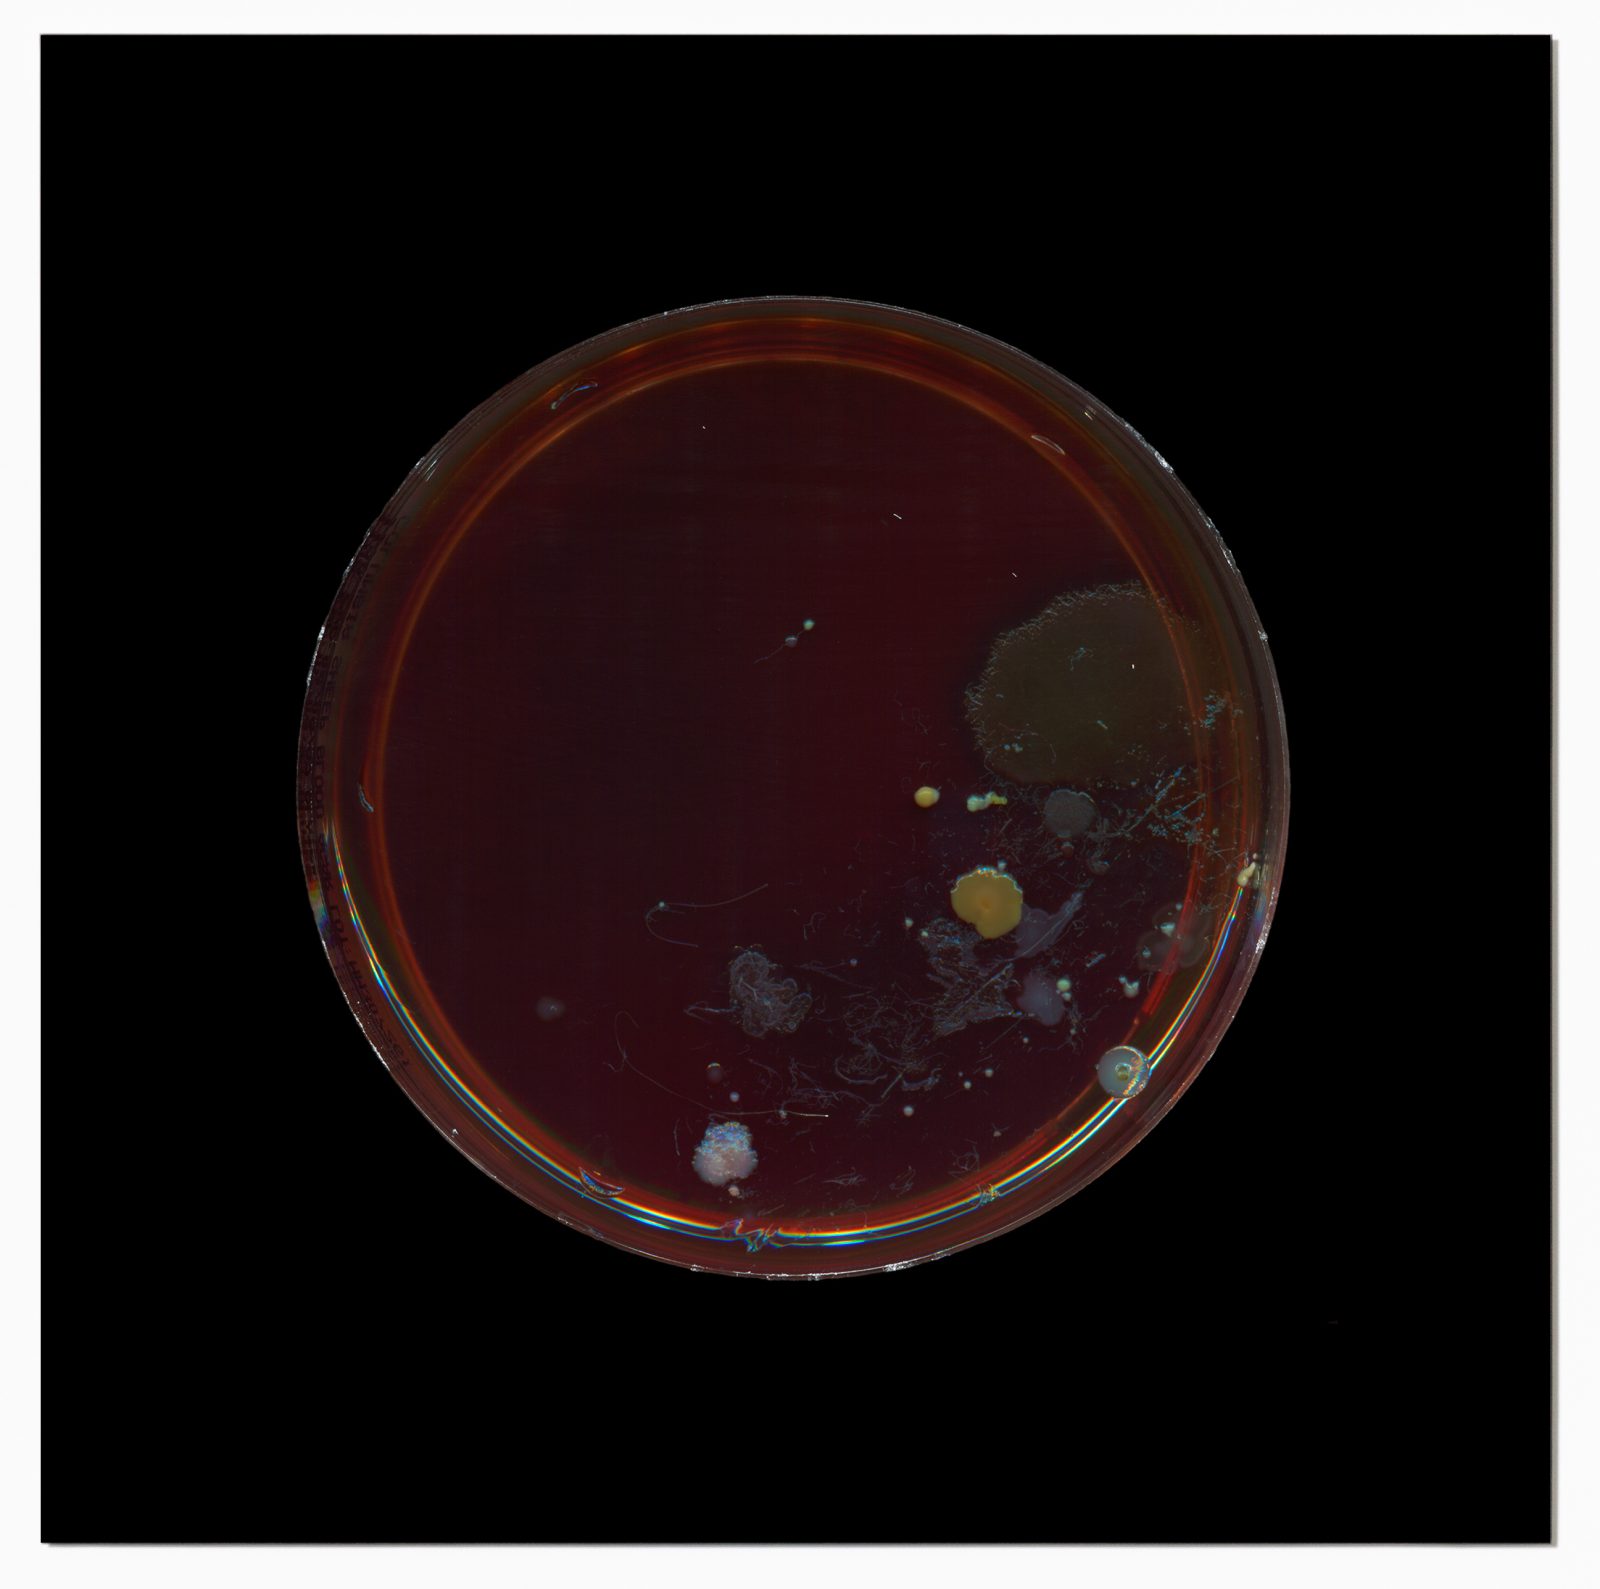
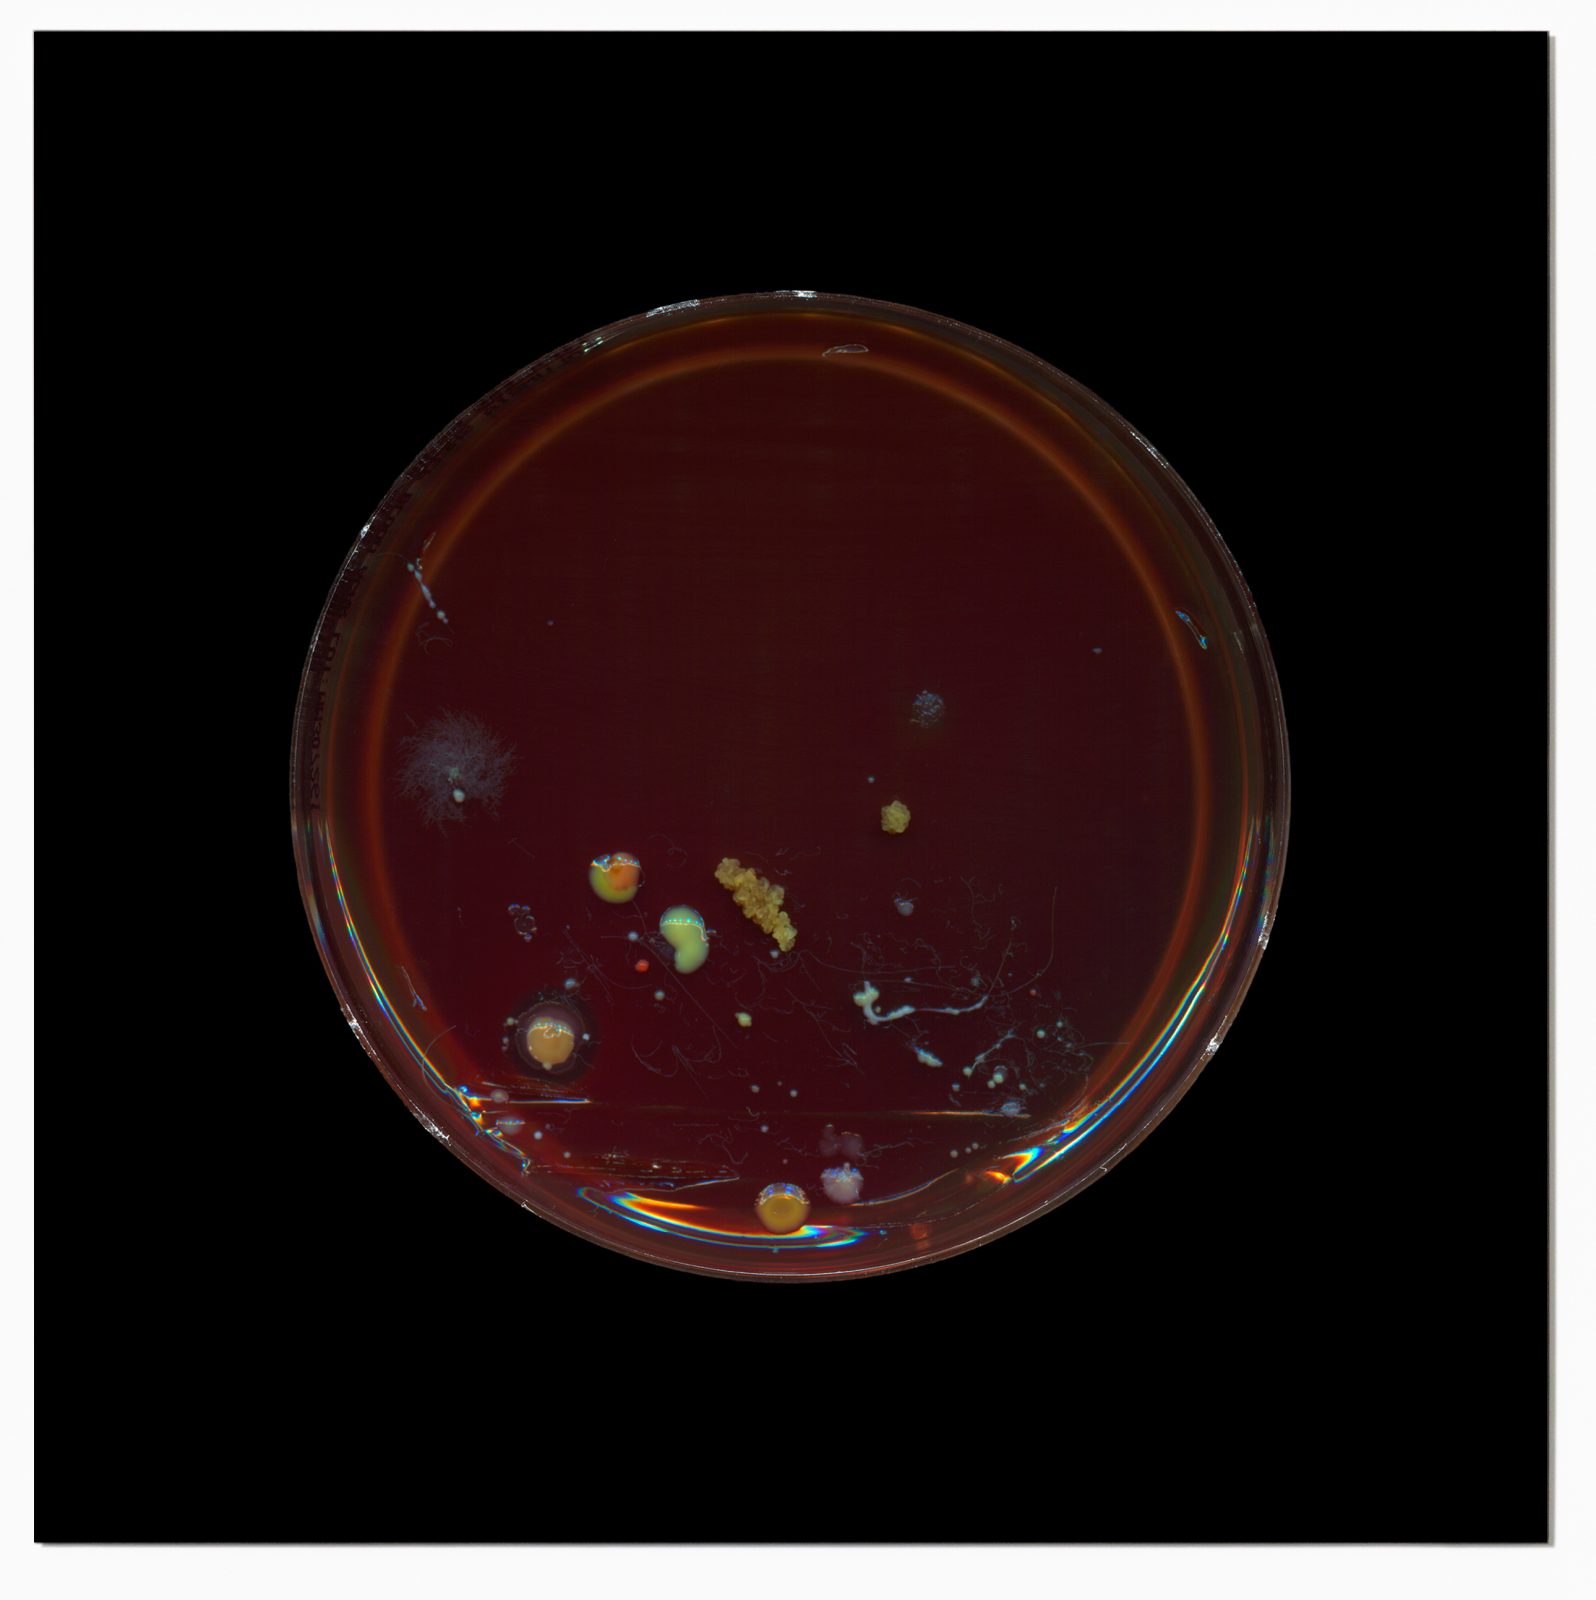
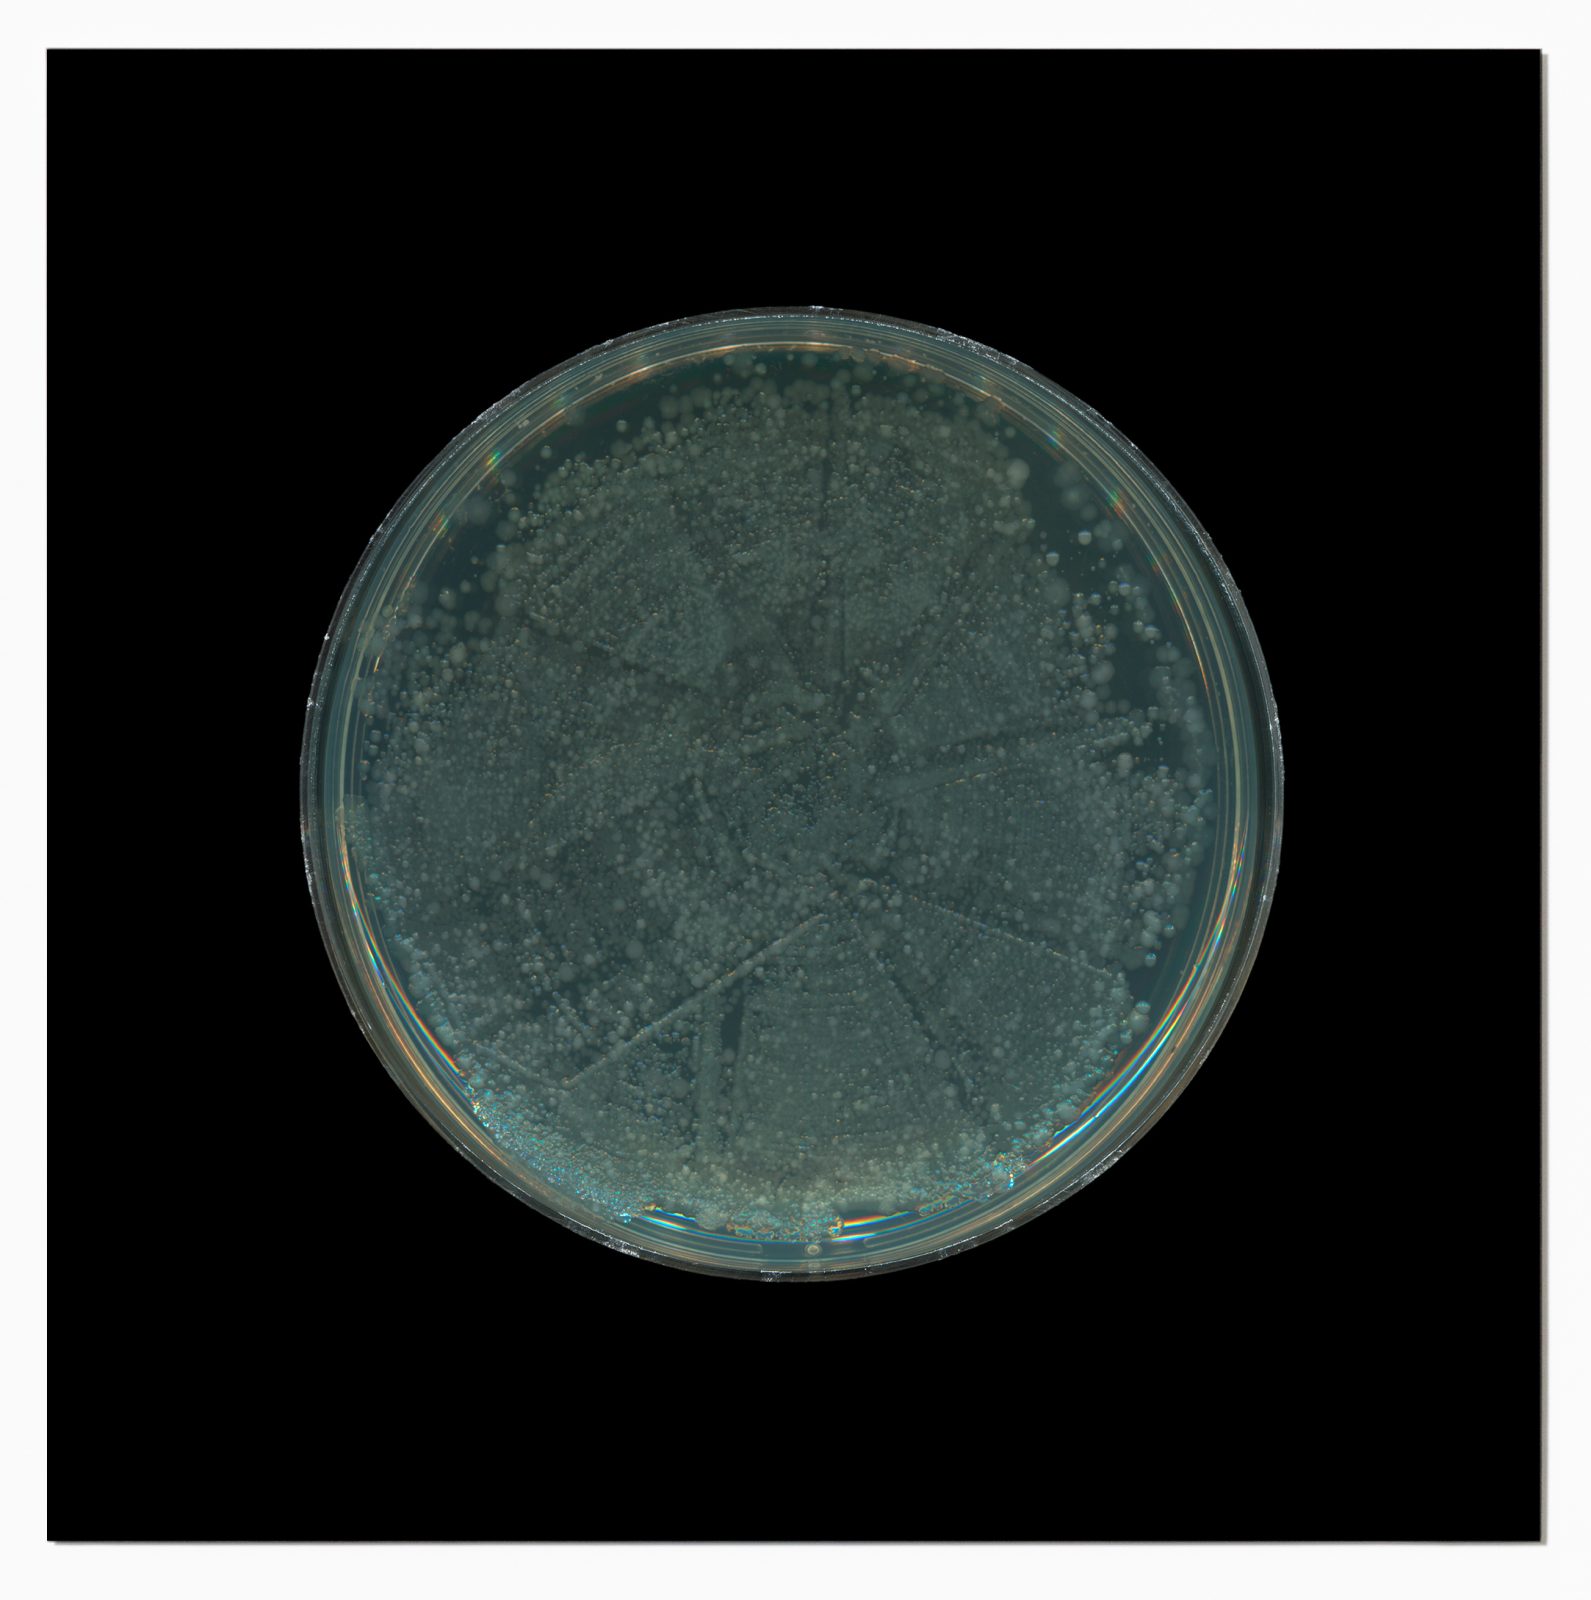
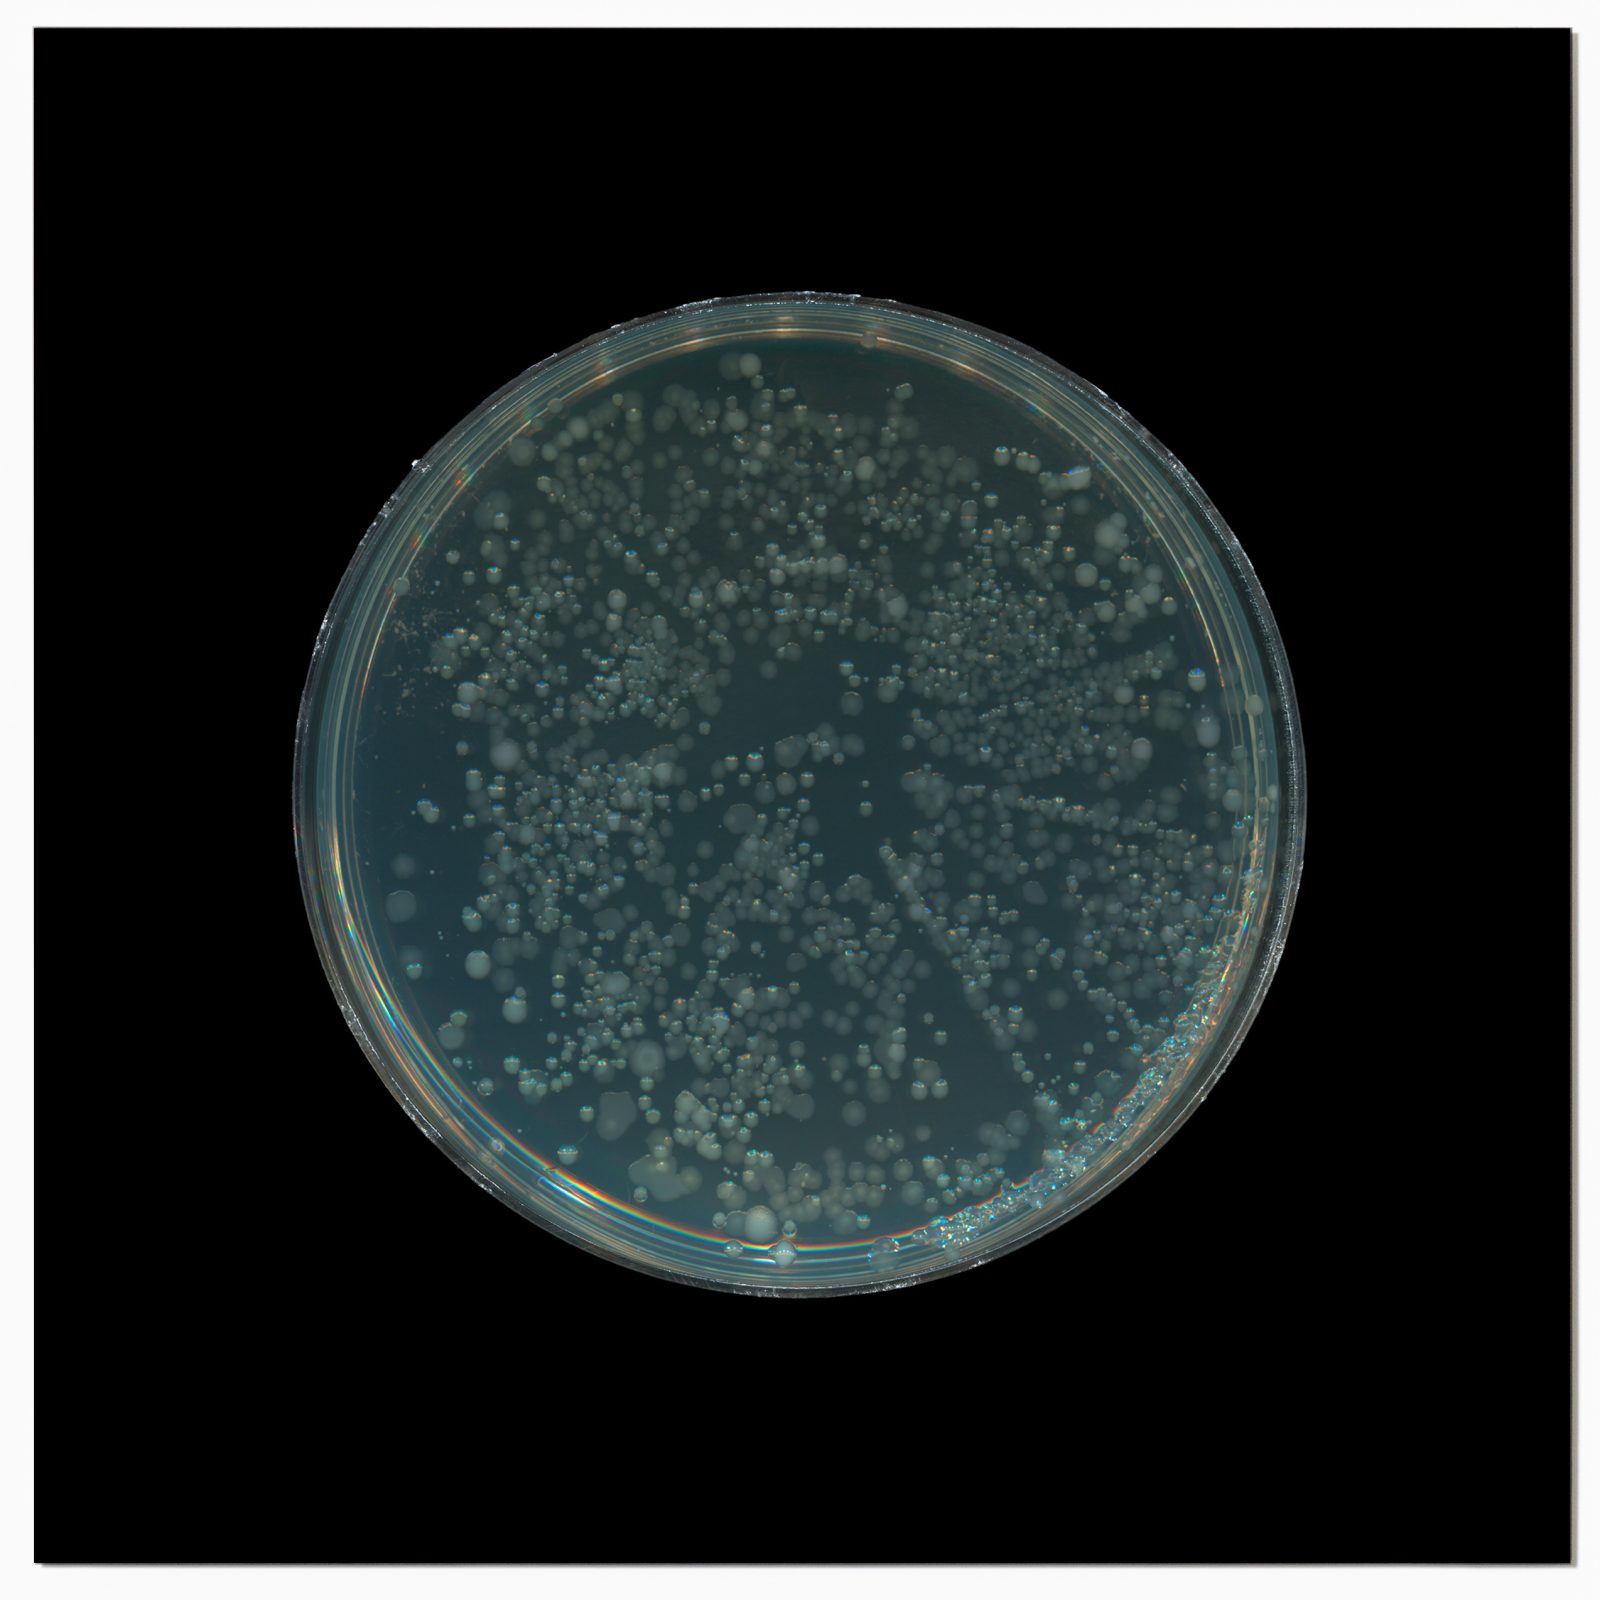
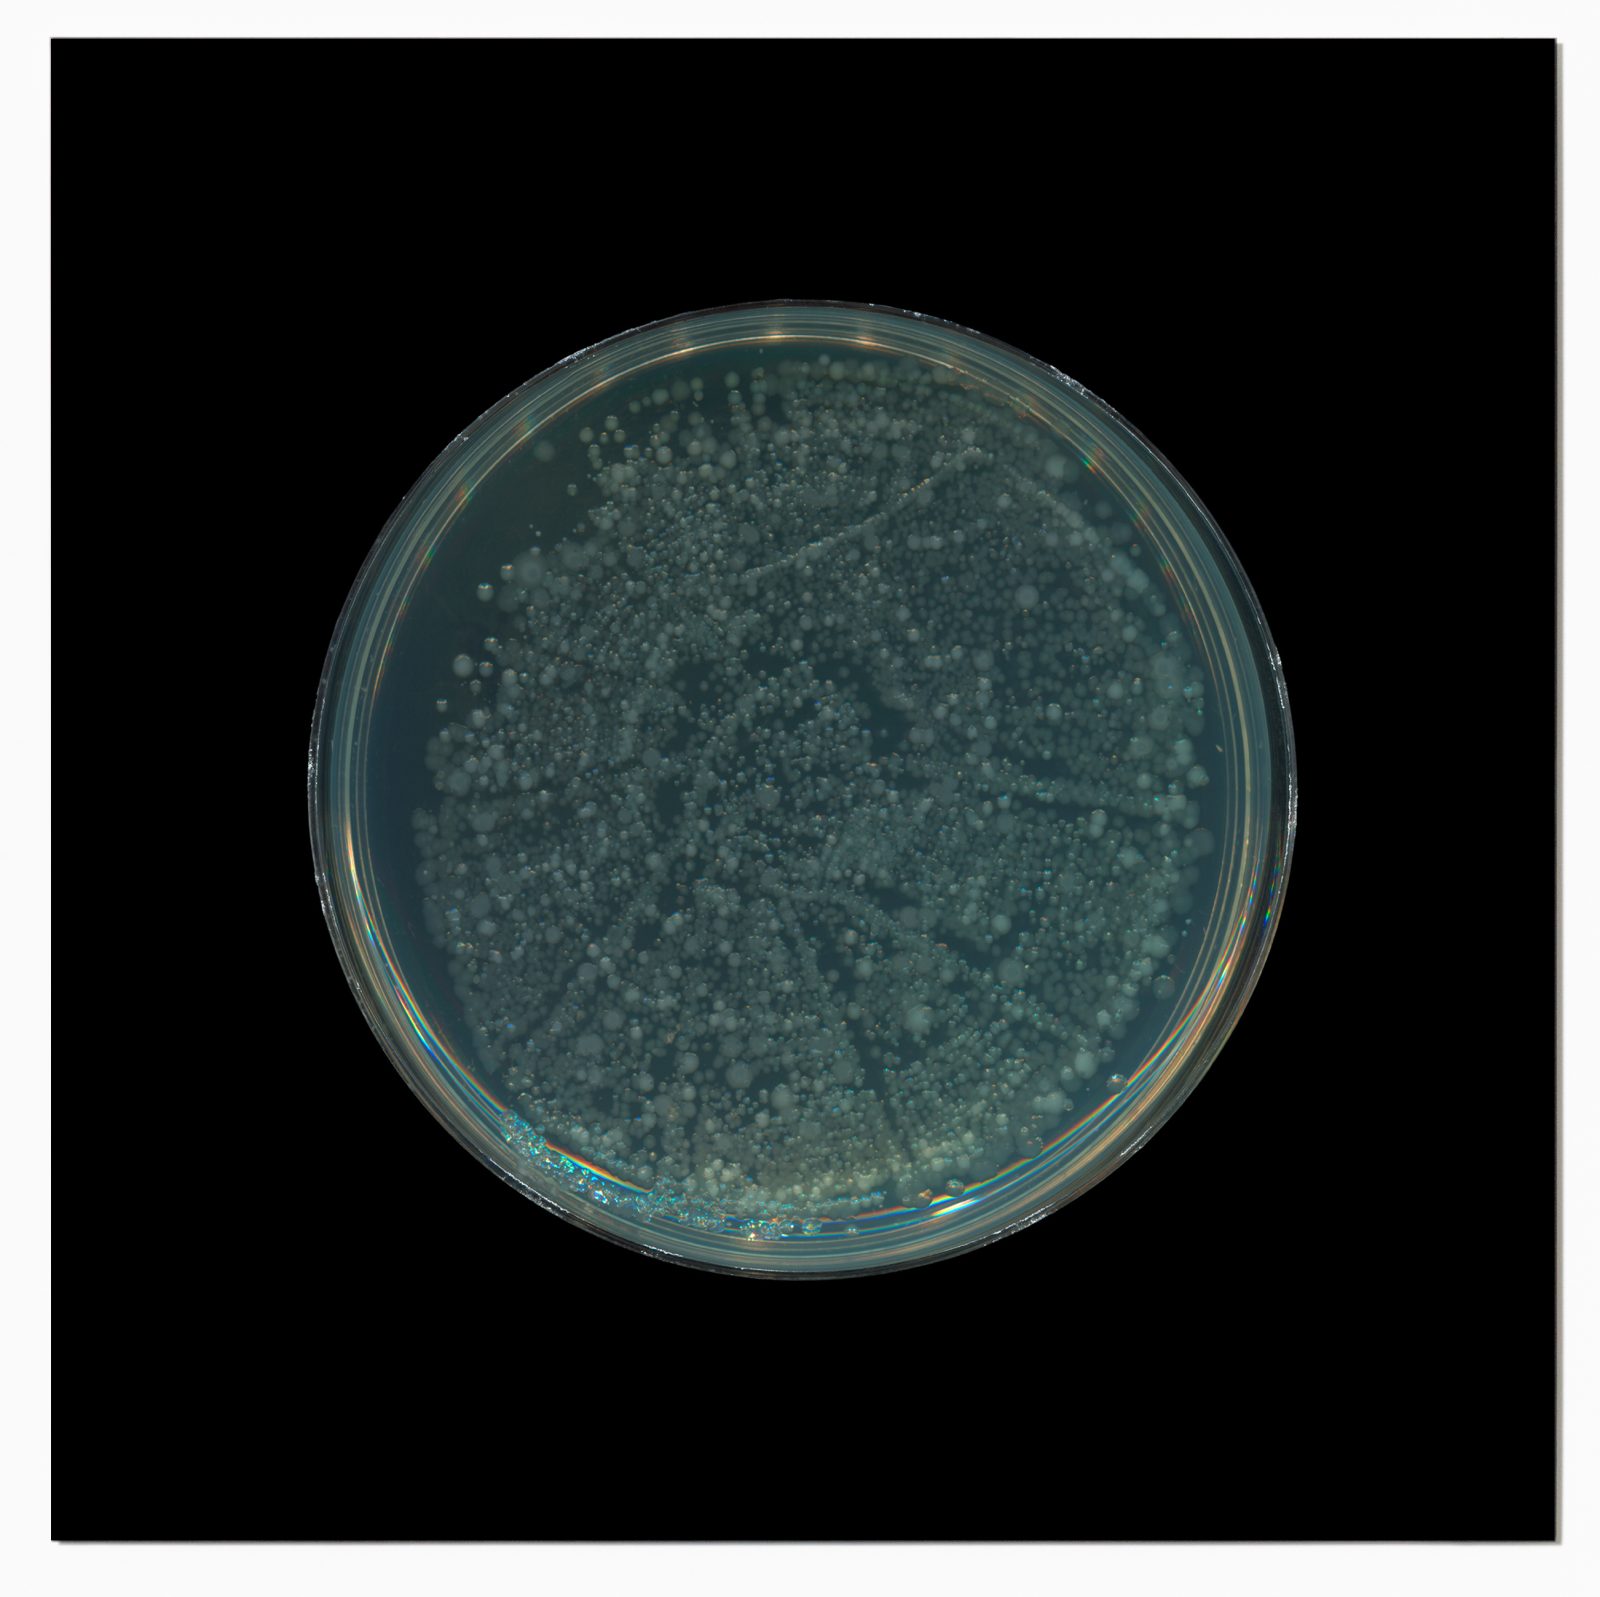
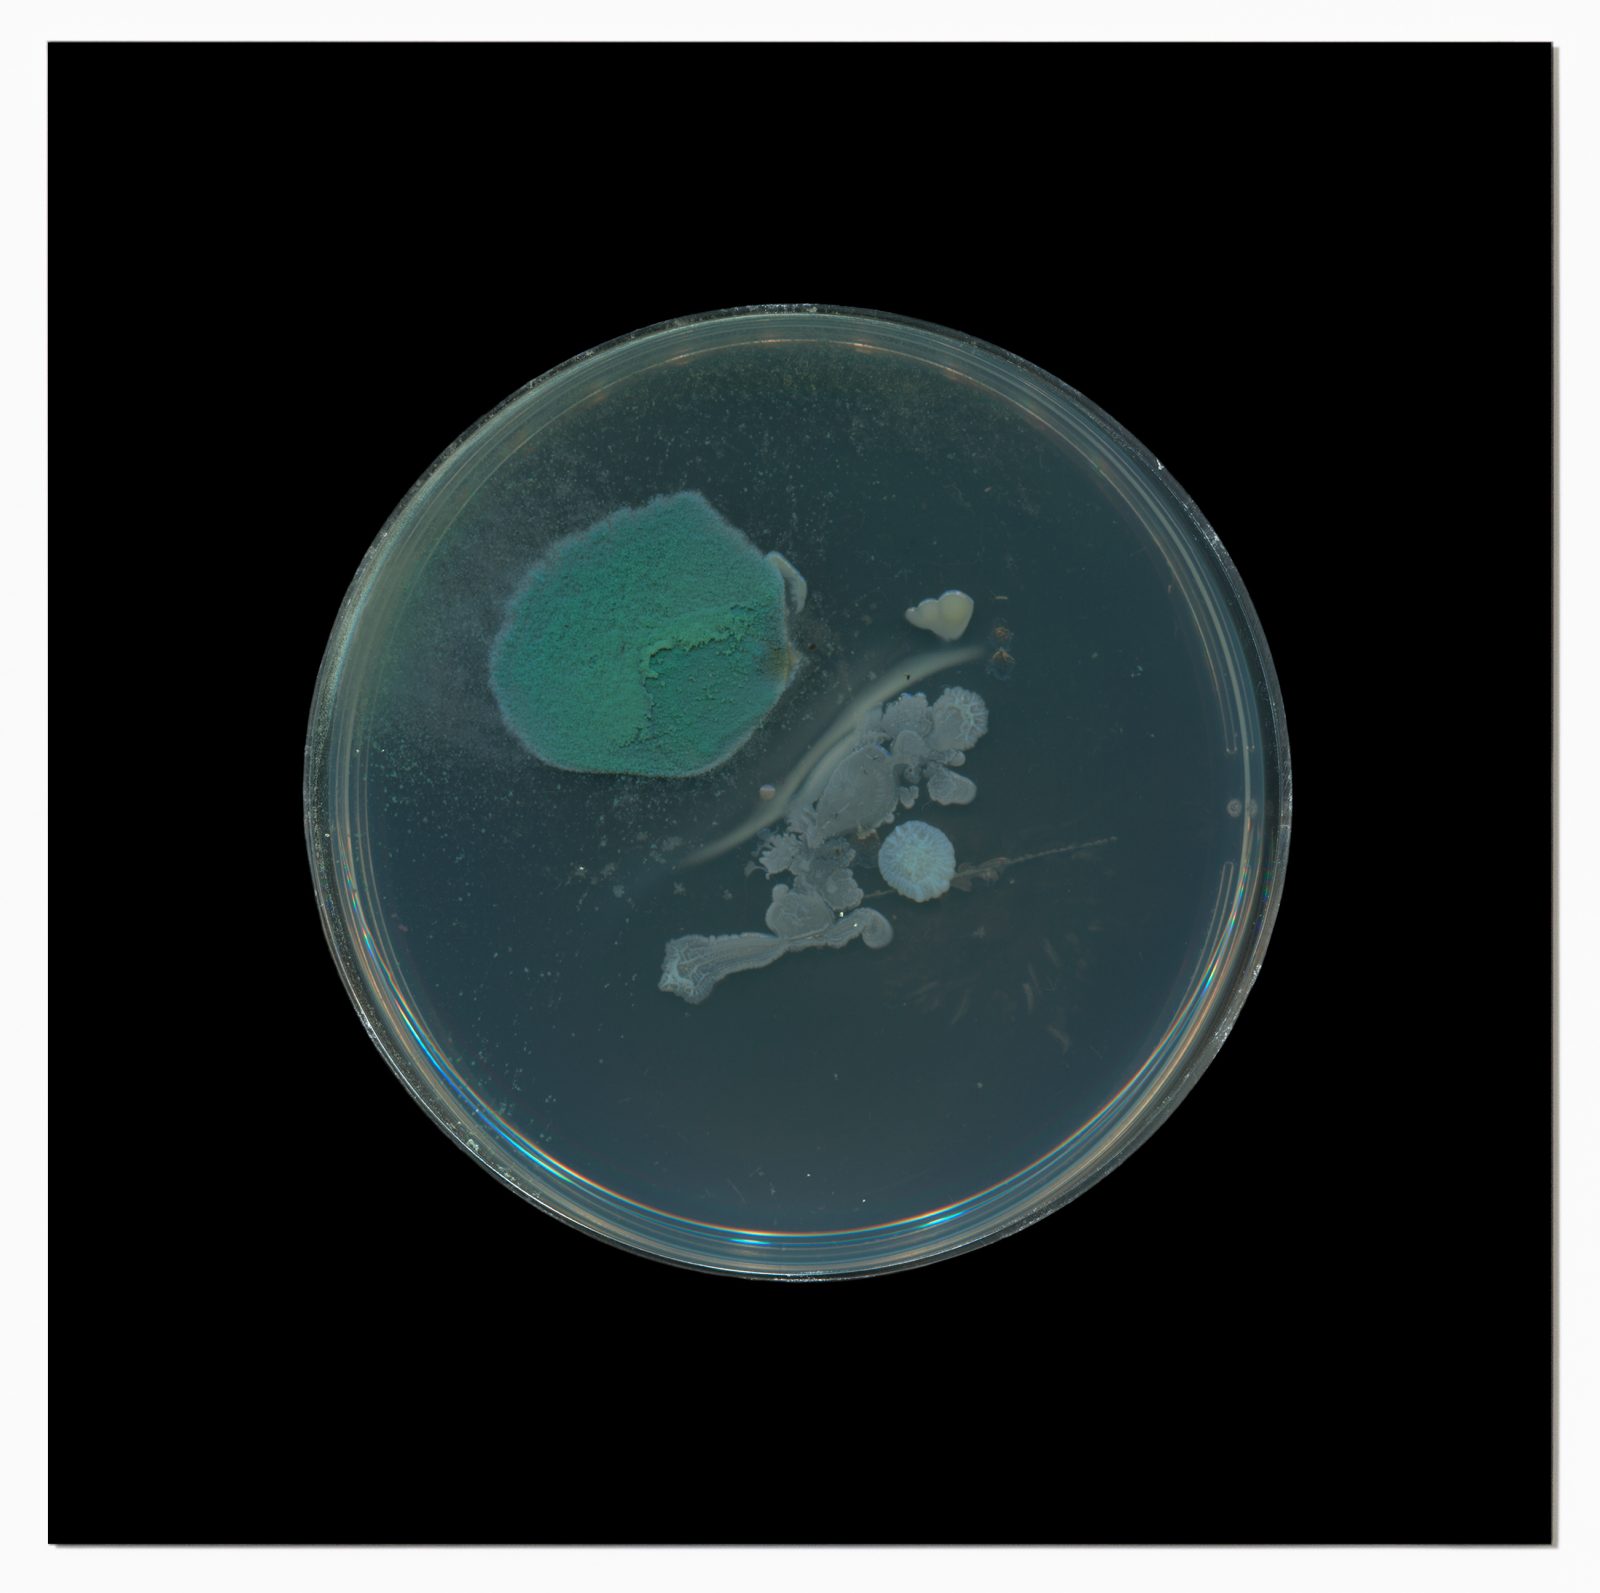

Dane Mitchell
Archive of Dust, Room 18
15 November - 20 December 2025
Archive of Dust, Room 18 stems from a project artist Dane Mitchell began in 2001, involving the ongoing collection of dust from museums and galleries around the world from which bacteria is cultured. The longevity of Dane Mitchell’s accumulation of dust over nearly 25 years now contains samples from hundreds of institutions. Archive of Dust, Room 18 focusses on dust collected in Room 18 at the British Museum, the current resting place of The Parthenon Marbles.
Alongside the series of 12 photographic works produced from scans of bacterial growth grown from the dust gathered in Room 18 is Room 18 Air Sample, 2024 which captures the atmospheric essence of Room 18. Encapsulating the air in a hermetic void, Room 18 Air Sample holds a hollow space that suspends and captures a present. This present contains the imprint of bodies, bacteria, and objects, now held in a device designed to capture air samples for Gas Chromatography Mass Spectrometry analysis. Unlike traditional forms of cultural displacement, the air’s removal from Room 18 creates no void in its original location.
Room 18 Air Sample is also accompanied by a letter-work (a form first employed by the artist in 1997) to the British Museum requesting access to make the air capture and describe the future analysis and synthesis of the scent of Room 18.
Francesca Zappia





2001 - ongoing (collected 2023, cultured 2024, printed 2025)
Archive of Dust (British Museum, Room 18, no.1), 2001 - ongoing (collected 2023, cultured 2024, printed 2025)
Giclee print, aluminium
800mm x 800mm

Giclee print, aluminium
800mm x 800mm
Giclee print, aluminium
800mm x 800mm

Giclee print, aluminium
800mm x 800mm
Giclee print, aluminium
800mm x 800mm
Giclee print, aluminium
800mm x 800mm
Giclee print, aluminium
800mm x 800mm
Giclee print, aluminium
800mm x 800mm
Giclee print, aluminium
800mm x 800mm
Giclee print, aluminium
800mm x 800mm
Giclee print, aluminium
800mm x 800mm

Stainless steel, mild steel, air
235 x 235 x 340mm

Polyester
1450mm x 2140mm

Giclee print, aluminium
850 x 110mm